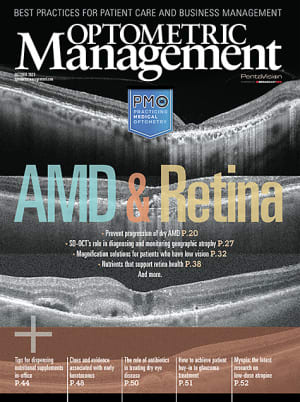

Features
Preventing Conversion to Advanced AMD
Focus on early and accurate diagnosis, monitoring, and comprehensive patient education
By AMANDA S. LEGGE, OD
SD-OCT's Role in Diagnosing and Monitoring Geographic Atrophy
Learn how this technology aids eye care providers in identification and, thus, intervention.
By Lisa M. Nijm, MD, JD
Empower Patients With Magnification Tools
Provide these basic solutions in the primary care setting
By BRYAN WOLYNSKI, OD, FAAO, ANDREA ZIMMERMAN, OD, FAAO
Educate Retina Patients on Eye-Healthy Nutrients
A review of the most important nutrients for the eye, and how to share this info with patients
By JENNIFER WADEMAN, OD
Dispense Ocular Nutritional Supplements from Your Practice
How nutritional supplements can benefit your patients and practices, and how to offer them in your clinic
By MARK E. SCHAEFFER, OD
Departments
LEADING OFF: Educate Patients On Solar Eclipse Risk
By Lindsey Getz, contributing writer
LEADING OFF: Prevent Scary Cosmetic Lens Stories This Halloween
By Shannon Simcox, contributing editor
LEADING OFF: CEO Challenge: My Challenge for You This Month: Condense Your Schedule
By STEVE VARGO, OD, MBA
CLINICAL: Myopia
Examining the latest research on low-dose atropine
By MARIA LIU, OD, PHD, MPH, MBA, FAAO
What's New
For Your Patients and Practice